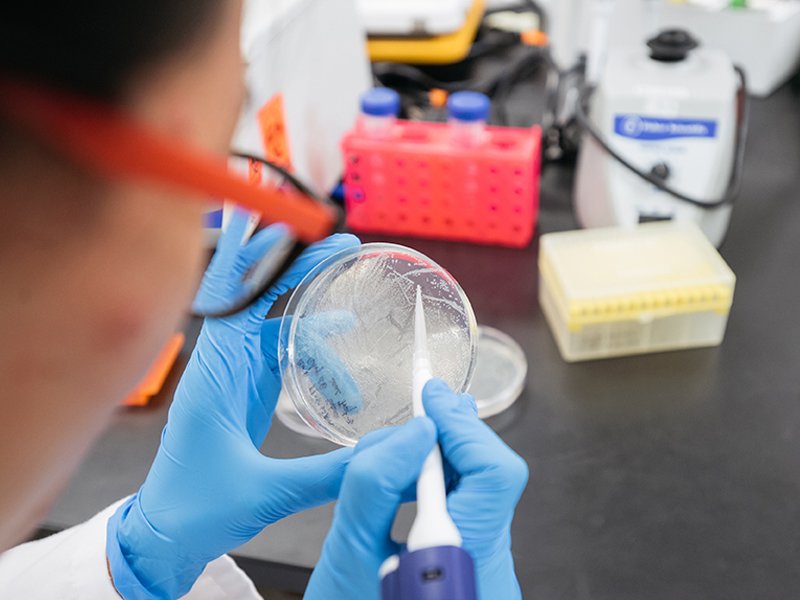

Regulatory affairs
Regulatory affairs (RA) professionals play critical roles in a pharmaceutical industry because it is concern about the healthcare product lifecycle, it provide strategic, tactical and operational direction and support for working within regulations to expedite the development and delivery of safe and effective healthcare products to individuals around the world. The role of regulatory affairs is to develop and execute a regulatory strategy to ensure that the collective efforts of the drug development team results in a product that is approvable by global regulators but is also differentiated from the competition in some way and also is to ensure that the company’s activities, from non-clinical research through to advertising and promotion, are conducted in accordance with the regulations and guidelines established by regulatory authorities.
Regulatory Affairs is an attractive career choice for graduate students from a scientific background who enjoy communication and team work, are comfortable with multi-tasking and are eager to expand their knowledge in the wide realms of the Pharmaceutical world. Regulatory Affairs is a rewarding, intellectually stimulating and highly regarded profession within pharmaceutical companies.